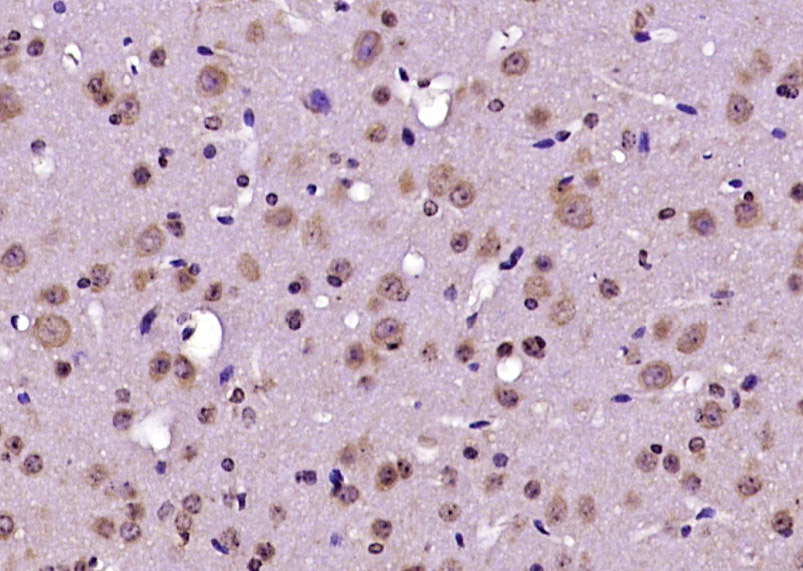

Immunofluorescent staining of human cell line MCF7 shows localization to cytosol.
Anti-RABGAP1 Antibody
HPA064860
ApplicationsImmunoCytoChemistry
Product group Antibodies
ReactivityHuman
TargetRABGAP1
Overview
- SupplierAtlas Antibodies
- Product NameAnti-RABGAP1 Antibody
- Delivery Days Customer4
- ApplicationsImmunoCytoChemistry
- CertificationResearch Use Only
- ClonalityPolyclonal
- ConjugateUnconjugated
- Gene ID23637
- Target nameRABGAP1
- Target descriptionRAB GTPase activating protein 1
- Target synonymsGAPCENA, TBC1D11, rab GTPase-activating protein 1, GAP and centrosome-associated protein, Rab6 GTPase activating protein, GAPCenA, TBC1 domain family, member 11, rab6 GTPase activating protein (GAP and centrosome-associated), rab6 GTPase-activating protein GAPCenA
- HostRabbit
- IsotypeIgG
- Protein IDQ9Y3P9
- Protein NameRab GTPase-activating protein 1
- Scientific DescriptionRecombinant Protein Epitope Signature Tag (PrEST) antigen sequence
- ReactivityHuman
- Storage Instruction-20°C,2°C to 8°C
- UNSPSC41116161